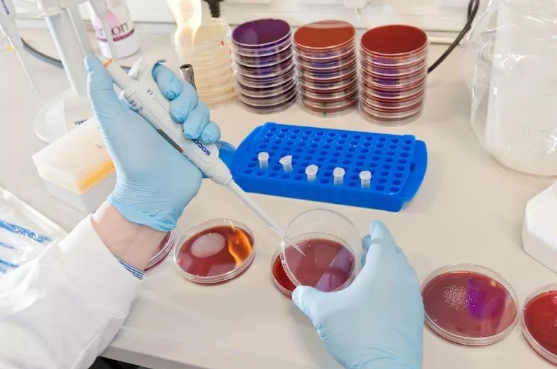

✨ 药剂和药理学学科全英排名数一数二
✨ 药学院研究实力全英排名第一
✨ 课程模块紧贴行业需求,科研知识技能与行业商务管理合一,培养多技能人才
德勤公司发布的《2019年全球生命科学展望报告》中指出,全球药品支出在快速增长;从2018年到2024年,药品的复合年增长率预计为6.4%,是2011-2017年1.2%的六倍。同时由于医学科技日益昌明,很多罕见病的秘密都逐渐被掀开;到2024年,罕见病用药行业预计将增速翻倍。
同时,随着数字化继续塑造着制药行业的各个角落,新一代初创企业和科技巨头纷纷涌现,威胁着制药行业的传统文化。这一方面促进了制药科技的不断创新发展,研究水平、精度和个性化都得到很大程度上的提高,另一方面也为制药行业的发展注入活力,促进了行业内部的管理制度的转型和改革。(资讯取材自前瞻网以及德勤报告)
随着经济和科技水平的不断发展,人们对健康的重视程度只会有增无减,这就意味着制药行业在未来必定是一片光明!在制药行业全球范围内,无论是科研开发,还是企业管理,都对人才有着巨大的需求。
因此为了培养新时代所需要的人才,Queen's精心打造了一门硕士课程:
工业药剂学硕士
MSc Inustrial Pharmaceutics
全球顶尖的药学院
学院研究实力妥妥的NO.1!
Queen's的药学院被公认为是英国药学教学和研究的领先中心,在该学科的排行榜中一直名列前茅。
学院研究领域主要涉及五大尖端研究主题
纳米医学和生物治疗
药物材料科学与制剂
药物传送系统和生物材料
感染和微生物抗性
医疗保健服务和药物优化
目标是通过的药品研究和开发操作水平,为世界各地的患者提供更好药物和服务。
英国女王大学 · 药学院
全英排名第1
2017《泰晤士报》优秀大学指南
顶尖学者讲师,全力助你成功!
药学院里汇聚有大量世界级的顶尖教研学者,他们都装备着强大的医药知识背景和制药科学能力,并已经准备好向学生们倾囊相授,为大家开启通向专业药剂行业的大门。
课程模块解析
Queen's紧贴全球制药行业发展动态,并结合学院强大教研实力基础,设计出这个工业药剂学硕士课程。目的是为有志投身制药行业的学生们提供多方面的专业知识和技能,涵盖从开发、测试、生产以及质量保证等一系列药物开发阶段,帮助大家在制药行业多元化发展。
从课程模块可以看出,既有药物研发生产等的理工技术型教学,又有数据管理、领导力培养、以及行业洞悉等商务管理类培训。
医药产品的表征方法
Characterisation Methos for Pharmaceutical Proucts
该模块介绍了药物产品定性和定量分析的各种技术,包括生理化学表征法、体外和体内测试,帮助学生了解现代产品开发和制造的解决方案。
药剂配方和生物制药产品
Formulation of Pharmaceutical & Biopharmaceutical Proucts
本模块涉及基础科学开发、高级药物配方、生物制药产品开发,以及各种剂型和给药途径的药物开发过程。课程中还会学习如何制作小分子以外不同剂型的药物,以及如何实现DNA药物、RNA药物和抗体配剂等。
制药和新兴技术
Pharmaceutical Manufacturing & Emerging Technologies
课程教学内容包括制药生产中关键性技术和先进制药工程概念,以及批量生产到连续生产、限元分析、个性化剂型配制等概念。
项目管理与企业家精神
Project Management & Entrepreneurship
培养具有领导力的人才是本课程最重要的亮点之一,课程内容除了教授如何把项目管理应用于制药项目,学院还会介绍创业有关的内容。通过学习本课程,学生还能收获含金量满满的英国特许管理协会的战略管理和领导能力CMI-7证书。
质量保证和法规事务
Quality Assurance & Regulatory Affairs
本模块旨在帮助学生了解制药行业所面临的挑战,为更好发现制药行业潜在机遇做好准备。
研究方法和数据管理
Research Methos & Data Management
学习制药研究最基本的技能,学习如何用业内最先进的方法进行分析管理和进行数据管理。
研究项目
Research Project
研究项目模块主题范围非常广泛,从理论到实践,帮助同学们发展在制药行业不同流程阶段所需的具体知识和技能。大家可以参与校方开展的研究计划,也可以选择基于工作的实践项目,更深入了解研究项目的商业应用实践。
广阔的发展空间
随着医药化工行业的不断兴起,制药产业对高端药剂学人才的需求只增不减!不论是制药业的研发、生产和监管领域,还是药物许可、卫生保健等政府监管机构都需要专业的药剂学人才来助阵。
经过多元综合的课程模块培养,工业药剂学毕业生不仅能掌握制药相关的高端理论知识和新兴研发技术,还熟悉医药企业的新药开发、审批和生产过程中的管理状况,成长为独当一面的工业药剂研究员,拥有在全球制药领域中寻求职业发展的最强竞争力。
如果想要继续进修博士学位,全英第一的英国女王大学药学院也是你最好的助跑平台!
入学要求
学 制:一年全日制
成绩要求:对等英国2.1学士学位
雅思要求:总分6.5(各项小分不低于6.0)
专业要求:化学、药学、制药科学、化学工程及生物等相关本科学术背景
制药教学科研实力超群
创新课程融合管理模块
助你在制药工业全面发展
成为独当一面的顶尖人才